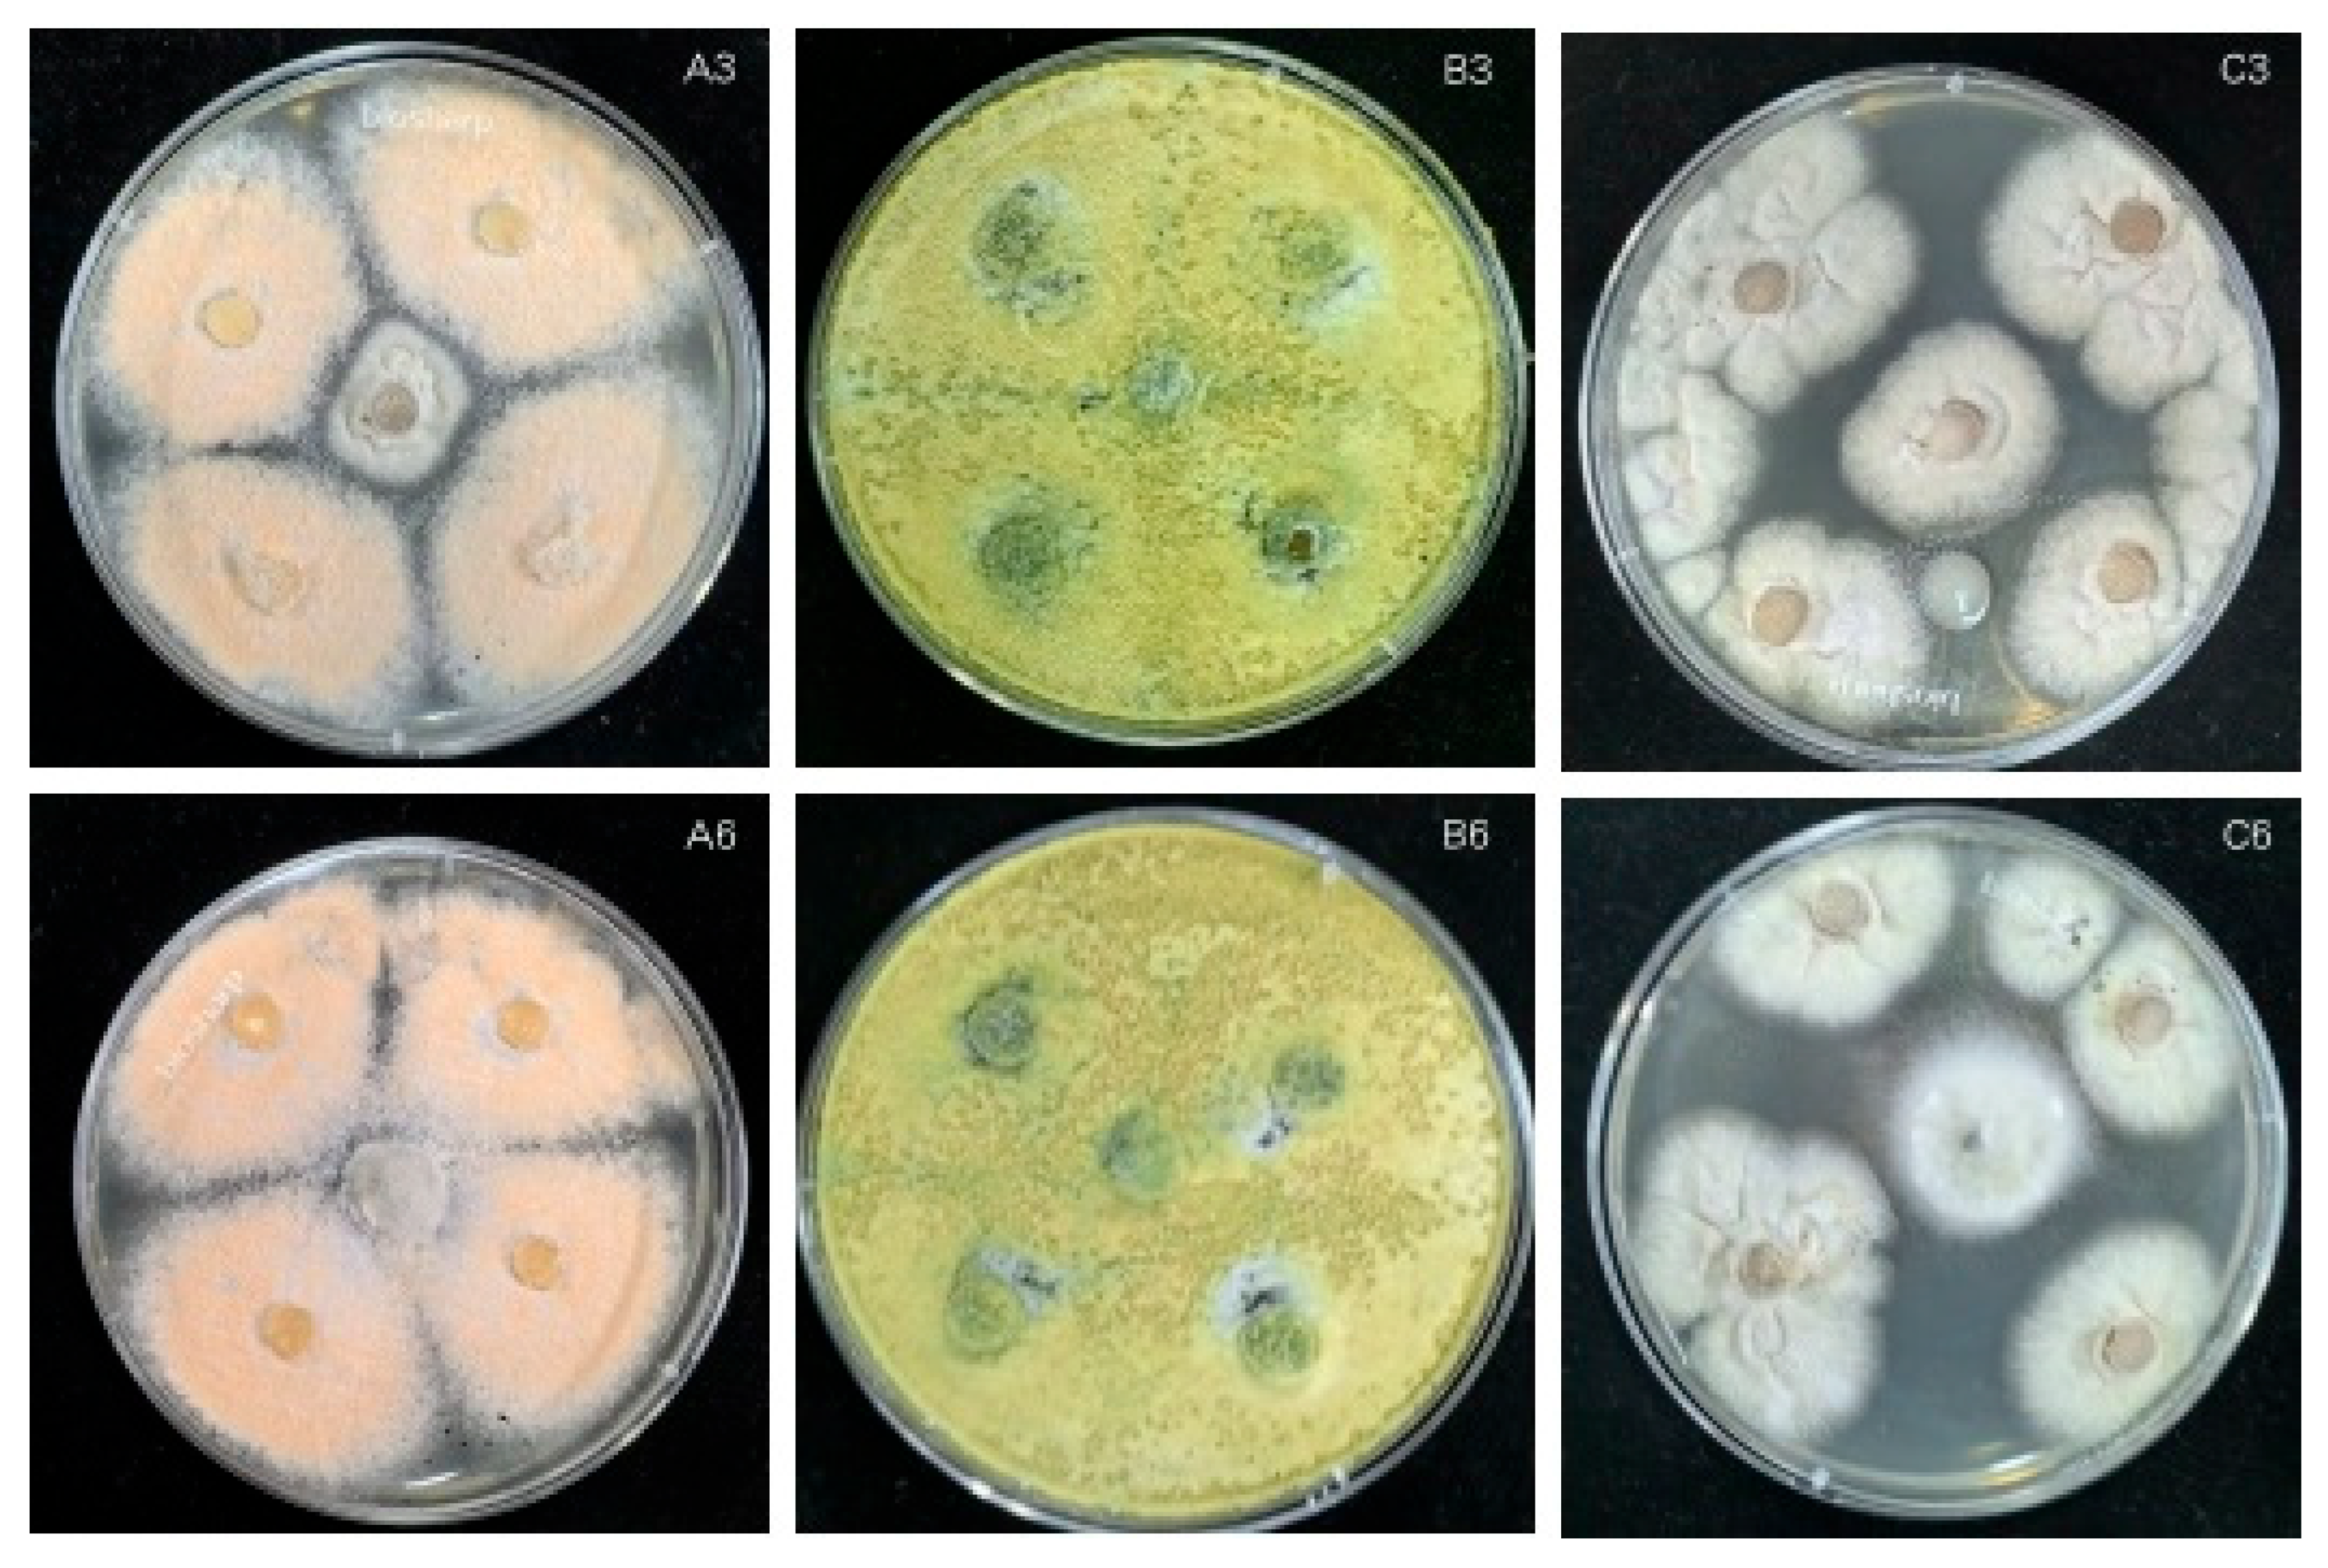
Agronomy 15 01776 g009
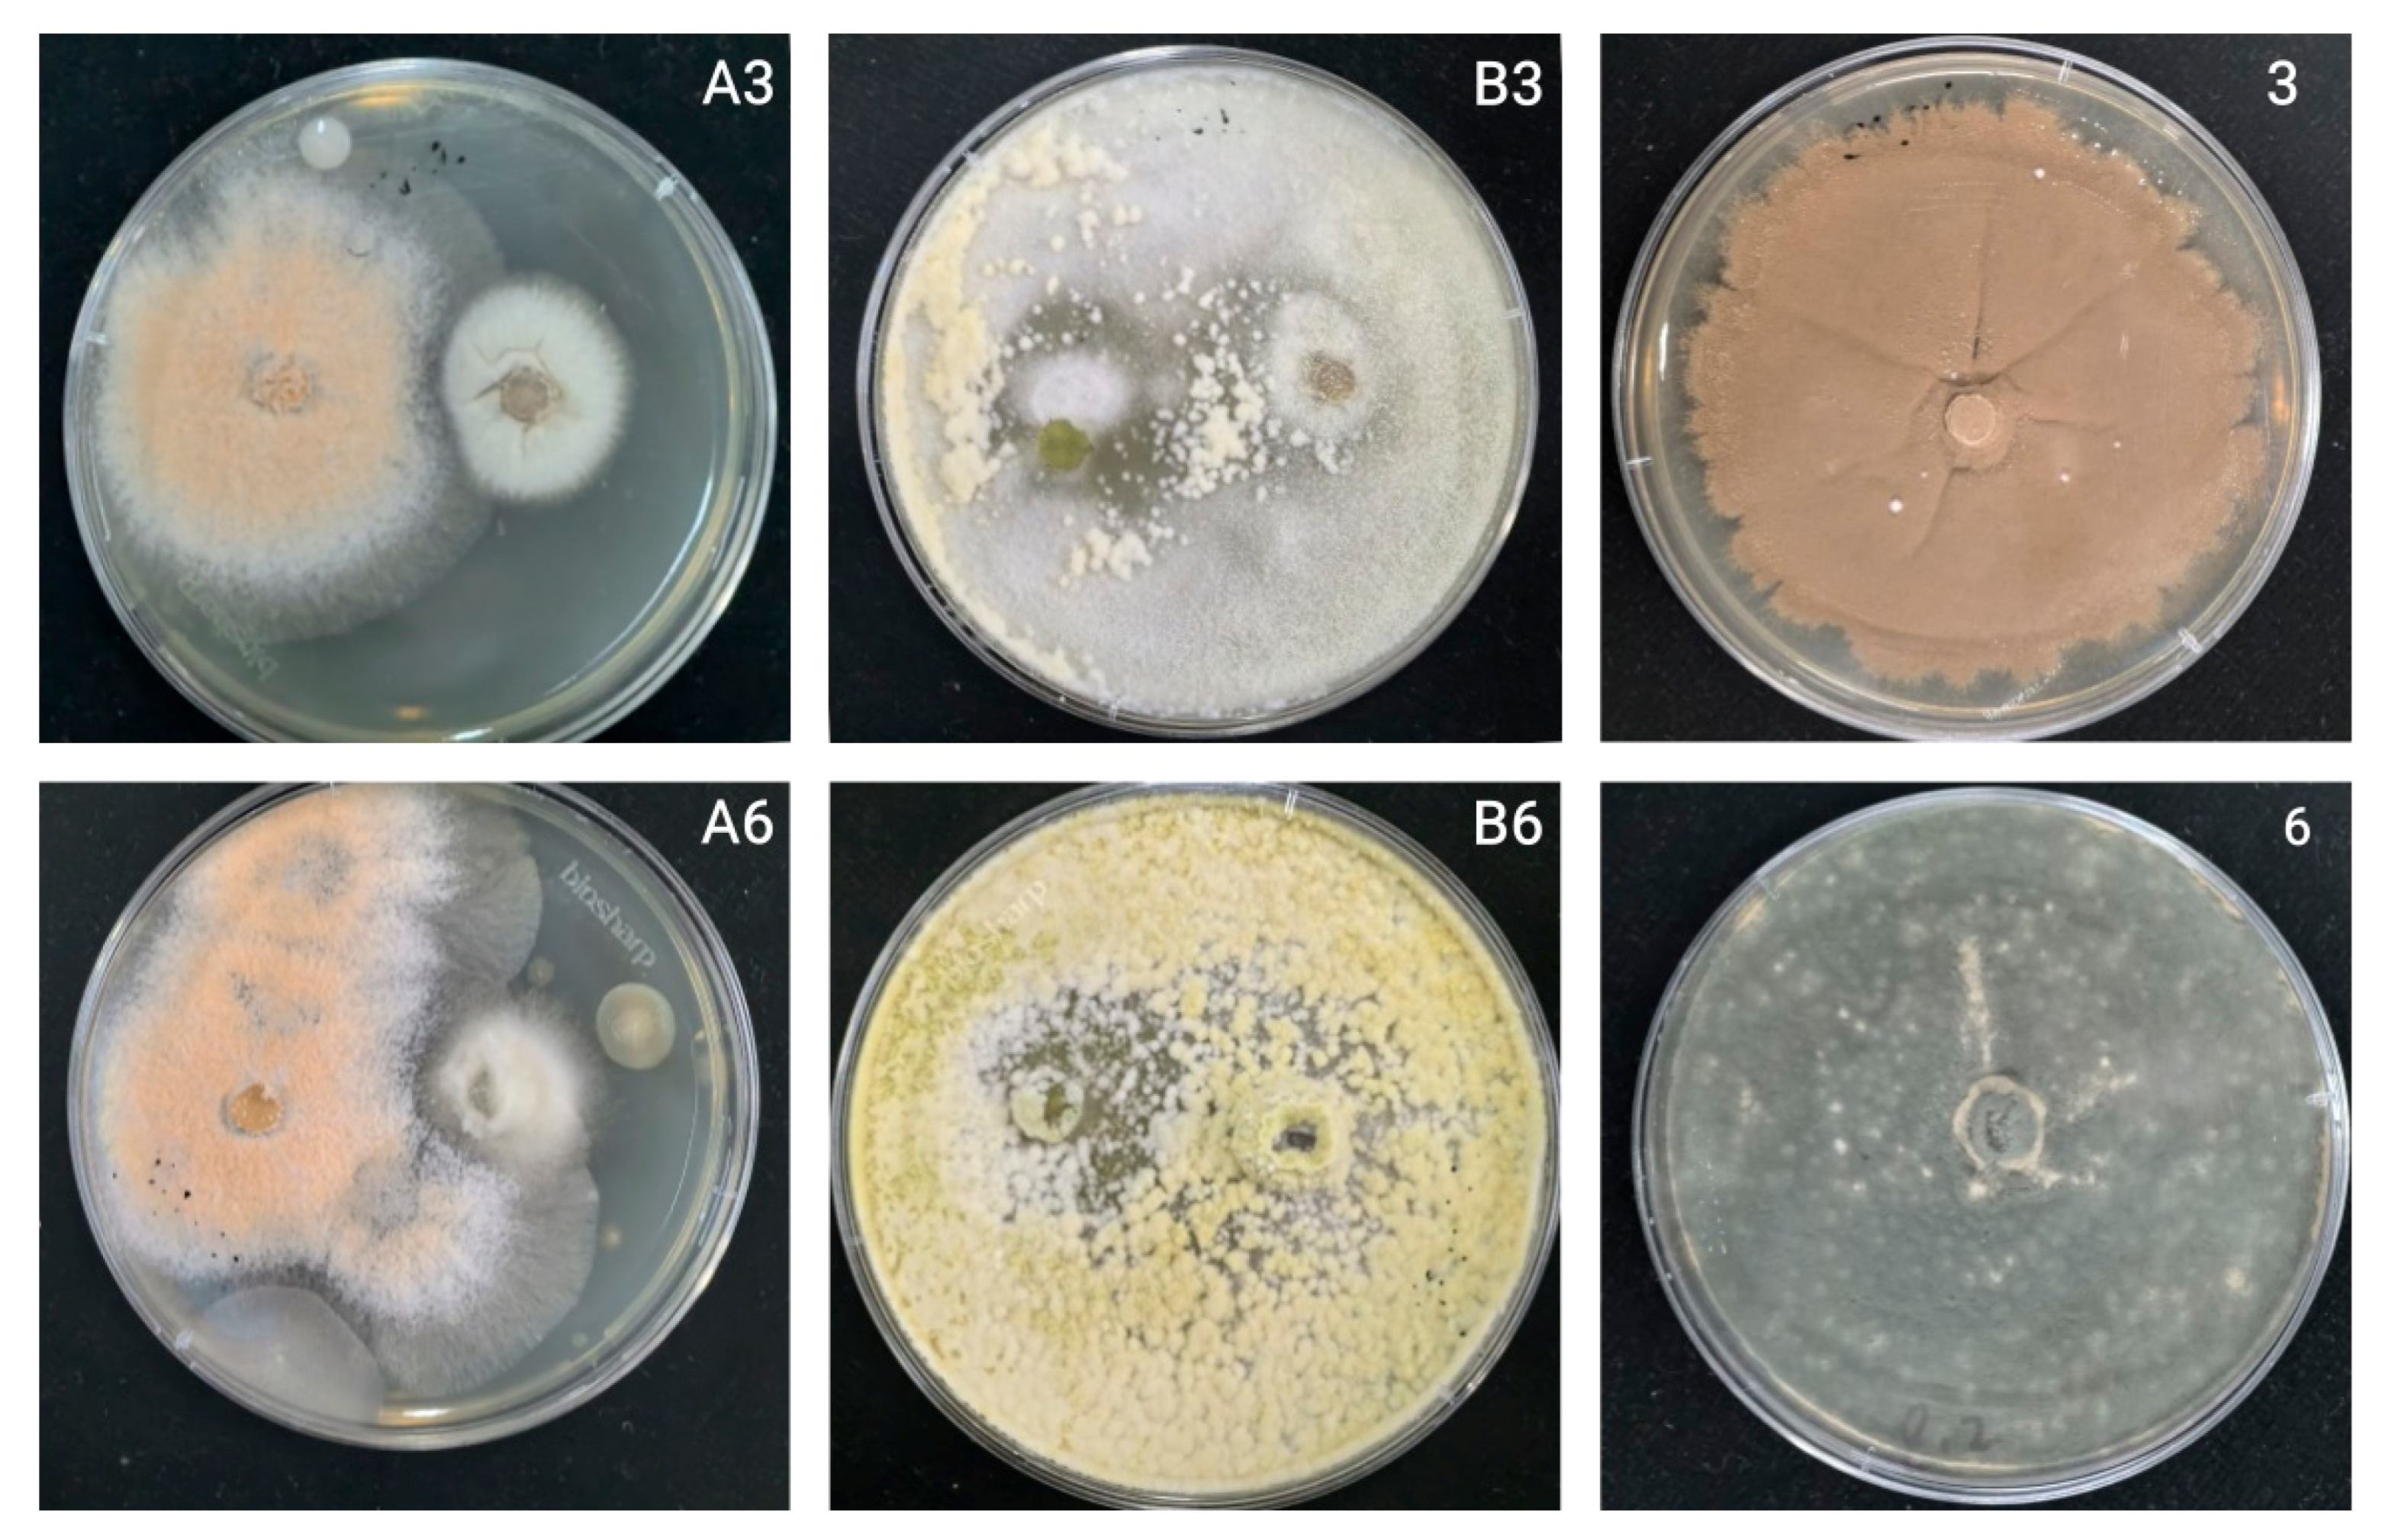
Agronomy 15 01776 g010

1. Introduction
Oat sheath rot disease is known to cause large reductions in commercial oat (Avena sativa) yields. At present, there remains relatively little research on the incidence of oat sheath rot, the extraction and identification of pathogens, or prevention and control measures, especially in China, a major oat exporter. This has resulted in a general failure to establish a corresponding prevention and control system. At the same time, excessive use of chemical agents can produce fungal resistance, leave pesticide residues, and cause other production or environmental issues.
Oat (
Avena sativa, Gramineae) is a major cereal crop whose leaves and straw are juicy and tender with good palatability [
1]. Moreover, the crude protein, crude fat, and nitrogen-free content of the straw is generally high, and fiber content, which is difficult to digest, is generally low. Oat is an excellent forage plant for supplementary feeding of livestock during the winter and spring and is critical for disaster-resistant livestock protection in pastoral areas [
2]. At present, oat is produced on a large scale both as an annual grain and as a forage crop in China. It exhibits significant drought resistance, cold tolerance, adaptability to barren conditions, and salt tolerance [
3] and plays a crucial role in agricultural rotation systems in China [
4,
5].
As the cultivation area of oat crops has expanded, the impact of various diseases on oat yield and quality has intensified, having now become one of the primary limiting factors for further development of the oat industry [
6]. Oat diseases directly reduce oat yield and quality, causing decreases in crude protein, fat, and soluble sugars while increasing the crude fiber content of oats, which together cause reduced palatability and digestibility [
7].
In recent years, a novel disease known as oat sheath rot was found on cultivated oats, wild oats, and highland barley in high-altitude (2400~3200 m) regions of central, western, and southern Gansu Province (i.e., in Tongwei, Tianzhu, and Hezuo) [
8]. A previous study found that this oat sheath rot generally occurred sporadically in fields, with rates of diseased ears in severely diseased fields reaching 20%~30% of all plants [
9]. The disease mainly occurs during the late growth period [
10], which endangers oat leaf sheaths. Once infected, plants show brown and irregularly shaped lesions. In severe cases, the disease can spread to the entire leaf sheath [
11,
12], resulting in leaf sheath desiccation or necrosis, thereby significantly impacting oat yield [
13].
At present, the use of chemical agents to control crop disease remains the main measure used during commercial agricultural production. However, the large-scale use of chemical pesticides is known to cause various problems, including induced resistance of pathogens to specific pesticides, changes in pathogen biotype, increased ineffectiveness of alternate fungicides, high levels of fungicide residues on postharvest products, and other negative effects on the environment and human health [
14], including environmental degradation, drug resistance, and large-scale soil hardening. During China’s promotion of eco-friendly agricultural and sustainable development policies, it is necessary to seek greener cultivation methods that can ensure both adequate yield and food and environmental safety [
15,
16,
17,
18]. Recent years have identified new ways to prevent and control plant disease by isolating and identifying pathogenic fungi from hosts and applying biocontrol fungal strains to inhibit pathogen proliferation and promote normal host growth [
19,
20,
21].
Therefore, this study conducted research into fungal biocontrol in the main oat-producing areas of China. By investigating disease in the field, we first isolated and identified pathogenic bacteria, then screened efficient and low-toxicity biocontrol fungi. In doing so we identified key pathogens causing oat sheath rot disease in major oat-producing areas and provide a basic protocol for the biological control of this disease.
4. Discussion
The interaction between plant growth and disease is a complex biological process [
16]. Plant diseases are often not caused by a single factor, but can be influenced by plant disease resistance, the environment of the planting area, the pathogenicity of the pathogen, and field management measures in place [
17,
18,
19,
20]. For example, in a previous study, Linghong [
21] examined samples of rice variety Jinyou 463 planted in Wuyuan, Xinfeng, and Taihe Counties, and found that Wuyuan County plants were the most severely affected by rice blast. In addition, meteorological factors are also known to influence plant disease. For example, the temperature, rainfall, and relative humidity of different planting sites can lead to differences in disease occurrence [
22]. By investigating the occurrence of powdery mildew in oat plants grown in 13 villages from eight different counties of Gansu Province, a study by Haoyang [
25] found that even when the same variety was present at different survey sites, the disease could take very different formats. Among the oat plants in the six townships, the authors recorded the highest incidence frequency in Majiazhuang Village (Tianzhu County), while the incidence of Baiyan 7 in Zhongtang Village (Yongdeng County) was the highest of the four planting areas.
Overall, meteorological, vegetation, and soil factors are the most tightly connected to the occurrence and prevalence of plant diseases. If the critical period of pathogen proliferation and infection coincides with suitable environmental conditions, the result can be an epidemic of plant disease [
21]. Atmospheric humidity and wind speed are also critically important for keeping cereal crops disease-free. As such, climate change can both directly affect pathogens but also make hosts more vulnerable to pathogens [
25]. When the temperature rises or rainfall conditions change, pathogen life history, oversummering behavior, and reproductive diffusion ability can change, thereby affecting the occurrence and development of plant disease [
22].
Crop plants can be affected by various diseases during any stage of their growth and development, mainly due to pathogen infection [
27]. In nature, many fungi can cause crop diseases, including oat sheath rot, with diseases caused by pathogenic fungi accounting for 70–80% of all plant diseases. Furthermore, fungal plant diseases are widely distributed, are generally rapid-onset, are sometimes difficult to spot, and can cause serious harm. Fungal pathogens often invade the apoplast or plant cells to obtain nutrients, thus establishing a parasitic relationship that can cause plant disease [
23,
28].
Plant–pathogen interactions are an important class of complex biological processes affecting crop production. The resistance of plants to pathogenic microorganisms is not only affected by their own genes but also by their adaptations to different regions and by human protocols for plant management [
29,
30,
31]. This study found slight differences in the types and quantities of pathogens extracted from each plant, which may reflect that pathogen infection is related to variety-specific disease resistance. In addition, disease severity can be related to sowing date, planting density, fertilizer application, plant variety, and irrigation management method. However, the pathogenic factors affecting plant disease and epidemics in different regions can also be quite different, and so the pathogenic microorganisms responsible in different regions may not be the same [
31]. In this study, we investigated diseases of the same oat variety in four different regions and found that the main causes of differences in disease emergence and format were environmental factors and management measures that differed among regions.
Oat sheath rot caused by
S. graminearum has been previously reported in oat crops [
8]. However, the two pathogens found in this study that were found to cause oat sheath rot have not been previously identified. This may be because different sites contain different pathogen living environments. In this study, the symptoms of sheath rot caused by pathogens were similar to those observed in the field but were also slightly different. For example, the central color of lesions of susceptible plants cultivated in the laboratory was darker: light beige or light brown, with the halo region being an even darker brown. Moreover, the lesion area overall was smaller than observed in the field. We speculate that these differences merely reflect differences between experimental and field growth environments [
32].
The growth rate of antagonistic fungi is an important indicator that they can compete with pathogenic fungi. Thus, the faster the rate of growth of antagonistic fungi, the more potent its effect on inhibiting the growth of pathogenic fungi [
33]. During the seven days of confrontation culture, the relative inhibition rates of the two antagonistic bacteria generally increased (
Figure 10). Only KN-WL3 showed a slight downward trend on the fifth day, but this sample showed an upward trend on the seventh day. This result may indicate that the nutrients in its culture medium were not distributed evenly when the PDA plate was manually inverted, resulting in a faster colony growth rate on the nutrient-enriched part of the PDA plate and a slower colony growth rate on the nutrient-scarce part.
Chemical pesticides are fast and effective, but pose significant biological safety and environmental pollution risks when used over the long term. Vogel et al. [
34] found that the detection probability of myclobutanil fungicide in rainwater collected during the rainy season in California was as high as 74%, with the concentrations of some samples reaching as high as 0.113 μg L-1. In a similar study, Ju et al. [
35] found that the total fungi, total bacteria, and biomass carbon content of fluvio-aquic soil from Henan (China) decreased significantly after myclobutanil spraying. Moreover, Yu et al. [
36] showed that triazole fungicides can cause thyroid endocrine disorders and affect gene transcription in zebrafish (
Barchydanio rerio) fry.
Fungi use many mechanisms to control plant disease, including competitive functions such as parasitism, antagonism and induction of disease resistance. In this study, the antagonistic fungus
T. harzianum was found to have a high biological control value; this is significant, since it is known to parasitize a variety of plant pathogens. The biological control effect of
T. harzianum has been verified by many previous studies. Bin and Pingzhi [
37,
38] showed that
T. harzianum can improve the rhizosphere soil environment, mainly by regulating nutrient competition, spatial competition, and heavy parasitism on tomato gray mold, leaf mold,
Fusarium wilt, and brown spot. Lakhdari et al. [
39] showed that
T. harzianum could control tomato
Fusarium wilt by inhibiting the growth of
Fusarium oxysporum mycelia. Another study by Ahmad et al. [
40] showed that
T. harzianum inhibited the reproduction of tomato root-knot nematodes, while a different study looking at pepper showed that
Trichoderma harzianum had an inhibitory effect on cucumber gray mold, powdery mildew,
Rhizoctonia solani,
Fusarium wilt, root rot, and root-knot nematodes, as well as a strong inhibitory effect on
Phytophthora capsici, small sclerotia,
Rhizoctonia solani, and other soil-borne pathogens [
41]. Reports on the use of
Trichoderma to control crop
Fusarium wilt have mainly focused on
T. harzianum,
T. asperellum [
42], and
T. viride [
43]. However, there are relatively few reports of
Trichoderma koningii being used to prevent
Fusarium wilt. In this study,
Trichoderma koningii was used to inhibit oat sheath rot, and it showed a remarkable biocontrol effect.
G. roseum is another important biocontrol fungus. It has many advantages, including a fast growth rate, production of a large number of spores, and strong antagonistic ability. In addition to its heavy parasitism, antibiosis, bacteriolysis, and competitive inhibition effects against pathogens, it can also induce systemic resistance in target plants [
44]. One study reported that
Gliocladium roseum shows a strong parasitic ability and was able to inhibit a pathogen causing fruit branch disease by more than 60% [
45]. Therefore, at present, accelerating the research of biocontrol agents and strengthening their production efficiency are top priorities. Moreover, developing the capacity to culture but inhibit the development of pathogens is required for testing biological control agents [
46].
At present, few studies have examined the prevention and control of oat sheath rot. Therefore, our results provide a novel theoretical basis for further prevention and control of oat sheath rot.